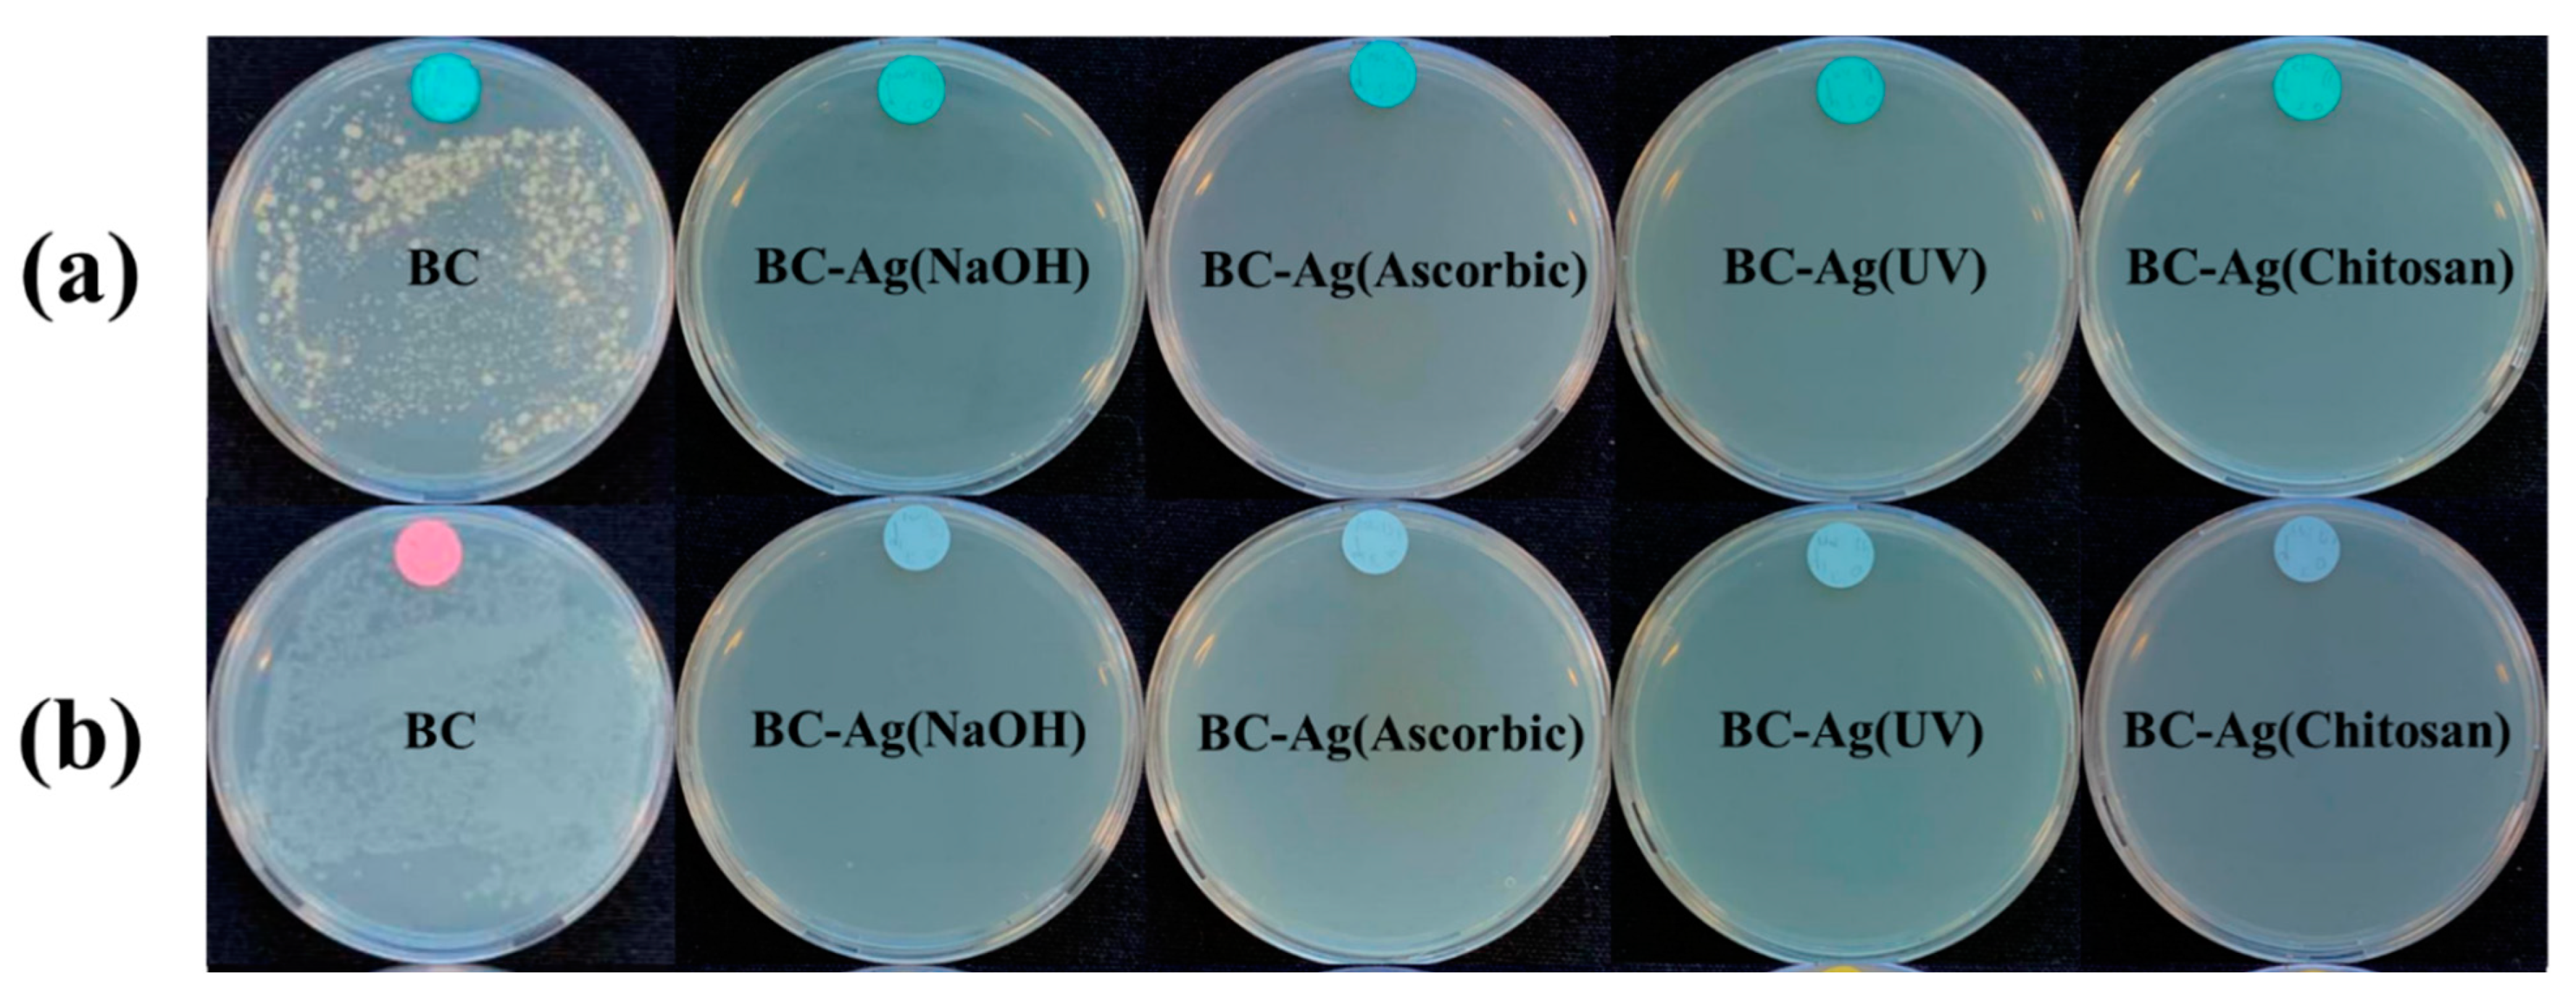
Polymers 15 02996 g010 Polymers 15 02996 g010

Effect of Reduction Methods on the Properties of Composite Films of Bacterial Cellulose-Silver Nanoparticles
Abstract
1. Introduction
2. Materials and Methods
2.1. Materials
2.2. Preparation and Purification of BC
2.3. Impregnation and Reduction of Ag Ions in BC
2.4. Physical and Chemical Characterization
2.5. Biological Characterization
3. Results and Discussion
3.1. Impregnation and In Situ Reduction of Ag Ions
3.2. Morphology
3.3. FTIR Analysis
3.4. Crystallinity
3.5. Mechanical Properties
3.6. Thermal Properties
3.7. Electrical Properties
3.8. Water Absorption Capacity
3.9. Antibacterial Activity
3.10. Advantages and Disadvantages of Each Reduction Method
4. Conclusions
Author Contributions
Funding
Institutional Review Board Statement
Data Availability Statement
Conflicts of Interest
References
- Habibi, Y.; Lucia, L.A.; Rojas, O.J. Cellulose nanocrystals: Chemistry, self-assembly, and applications. Chem. Rev. 2010, 110, 3479–3500. [Google Scholar] [CrossRef] [PubMed]
- Poddar, M.K.; Dikshit, P.K. Recent development in bacterial cellulose production and synthesis of cellulose based conductive polymer nanocomposites. Nano Sel. 2021, 2, 1605–1628. [Google Scholar] [CrossRef]
- Sintharm, P.; Phisalaphong, M. Green Natural Rubber Composites Reinforced with Black/White Rice Husk Ashes: Effects of Reinforcing Agent on Film’s Mechanical and Dielectric Properties. Polymers 2021, 13, 882. [Google Scholar] [CrossRef] [PubMed]
- Supanakorn, G.; Varatkowpairote, N.; Taokaew, S.; Phisalaphong, M. Alginate as Dispersing Agent for Compounding Natural Rubber with High Loading Microfibrillated Cellulose. Polymers 2021, 13, 468. [Google Scholar] [CrossRef]
- Fortunati, E.; Kenny, J.M.; Torre, L. 5—Lignocellulosic materials as reinforcements in sustainable packaging systems: Processing, properties, and applications. In Biomass, Biopolymer-Based Materials, and Bioenergy; Verma, D., Fortunati, E., Jain, S., Zhang, X., Eds.; Woodhead Publishing: London, UK, 2019; pp. 87–102. [Google Scholar]
- Phomrak, S.; Phisalaphong, M. Reinforcement of Natural Rubber with Bacterial Cellulose via a Latex Aqueous Microdispersion Process. J. Nanomater. 2017, 2017, 4739793. [Google Scholar] [CrossRef]
- Dikshit, P.K.; Kim, B.S. Bacterial cellulose production from biodiesel–derived crude glycerol, magnetic functionalization, and its application as carrier for lipase immobilization. Int. J. Biol. Macromol. 2020, 153, 902–911. [Google Scholar] [CrossRef]
- Blanco Parte, F.G.; Santoso, S.P.; Chou, C.C.; Verma, V.; Wang, H.T.; Ismadji, S.; Cheng, K.C. Current progress on the production, modification, and applications of bacterial cellulose. Crit. Rev. Biotechnol. 2020, 40, 397–414. [Google Scholar] [CrossRef] [PubMed]
- Ciechańska, D. Multifunctional bacterial cellulose/chitosan composite materials for medical applications. Fibres Text. East. Eur. 2004, 12, 69–72. [Google Scholar]
- Evans, B.R.; O’Neill, H.M.; Malyvanh, V.P.; Lee, I.; Woodward, J. Palladium-bacterial cellulose membranes for fuel cells. Biosens. Bioelectron. 2003, 18, 917–923. [Google Scholar] [CrossRef]
- Choi, Y.-J.; Ahn, Y.; Kang, M.-S.; Jun, H.-K.; Kim, I.; Moon, S.-H. Preparation and characterization of acrylic acid-treated bacterial cellulose cation-exchange membrane. J. Chem. Technol. Biotechnol. 2004, 79, 79–84. [Google Scholar] [CrossRef]
- Jeon, J.-H.; Oh, I.-K.; Kee, C.-D.; Kim, S.-J. Bacterial cellulose actuator with electrically driven bending deformation in hydrated condition. Sens. Actuators B Chem. 2010, 146, 307–313. [Google Scholar] [CrossRef]
- Shah, N.; Ul-Islam, M.; Khattak, W.A.; Park, J.K. Overview of bacterial cellulose composites: A multipurpose advanced material. Carbohydr. Polym. 2013, 98, 1585–1598. [Google Scholar] [CrossRef] [PubMed]
- Maria, L.; Santos, A.; Oliveira, P.; Valle, A.; Barud, H.; Messaddeq, Y.; Ribeiro, S. Preparation and Antibacterial Activity of Silver Nanoparticles Impregnated in Bacterial Cellulose. Polim.-Cienc. E Tecnol.-Polim. 2010, 20, 72–77. [Google Scholar] [CrossRef]
- Ul-Islam, M.; Khan, T.; Park, J.K. Water holding and release properties of bacterial cellulose obtained by in situ and ex situ modification. Carbohydr. Polym. 2012, 88, 596–603. [Google Scholar] [CrossRef]
- Sintharm, P.; Nimpaiboon, A.; Liao, Y.-C.; Phisalaphong, M. Bacterial cellulose reinforced with skim/fresh natural rubber latex for improved mechanical, chemical and dielectric properties. Cellulose 2022, 29, 1739–1758. [Google Scholar] [CrossRef]
- Taokaew, S.; Phisalaphong, M.; Zhang Newby, B.-M. Bacterial Cellulose: Biosyntheses, Modifications, and Applications. In Applied Environmental Materials Science for Sustainability; IGI Global: Pennsylvania, PA, USA, 2016; pp. 255–283. [Google Scholar]
- Phomrak, S.; Nimpaiboon, A.; Newby, B.-m.Z.; Phisalaphong, M. Natural Rubber Latex Foam Reinforced with Micro- and Nanofibrillated Cellulose via Dunlop Method. Polymers 2020, 12, 1959. [Google Scholar] [CrossRef]
- Bruna, T.; Maldonado-Bravo, F.; Jara, P.; Caro, N. Silver Nanoparticles and Their Antibacterial Applications. Int. J. Mol. Sci. 2021, 22, 7202. [Google Scholar] [CrossRef]
- Jeevanandam, J.; Krishnan, S.; Hii, Y.S.; Pan, S.; Chan, Y.S.; Acquah, C.; Danquah, M.K.; Rodrigues, J. Synthesis approach-dependent antiviral properties of silver nanoparticles and nanocomposites. J. Nanostruct. Chem. 2022, 12, 809–831. [Google Scholar] [CrossRef]
- Yang, G.; Xie, J.; Deng, Y.; Bian, Y.; Hong, F. Hydrothermal synthesis of bacterial cellulose/AgNPs composite: A “green” route for antibacterial application. Carbohydr. Polym. 2012, 87, 2482–2487. [Google Scholar] [CrossRef]
- Pal, S.; Nisi, R.; Stoppa, M.; Licciulli, A. Silver-Functionalized Bacterial Cellulose as Antibacterial Membrane for Wound-Healing Applications. ACS Omega 2017, 2, 3632–3639. [Google Scholar] [CrossRef]
- Yang, G.; Wang, C.; Hong, F.; Yang, X.; Cao, Z. Preparation and characterization of BC/PAM-AgNPs nanocomposites for antibacterial applications. Carbohydr. Polym. 2015, 115, 636–642. [Google Scholar] [CrossRef]
- Mutiara, T.; Sulistyo, H.; Fahrurrozi, M.; Hidayat, M. Facile route of synthesis of silver nanoparticles templated bacterial cellulose, characterization, and its antibacterial application. Green Process. Synth. 2022, 11, 361–372. [Google Scholar] [CrossRef]
- Seesuriyachan, P.; Kuntiya, A.; Hanmoungjai, P.; Techapun, C. Exopolysaccharide production by Lactobacillus confusus TISTR 1498 using coconut water as an alternative carbon source: The effect of peptone, yeast extract and beef extract. Songklanakarin J. Sci. Technol. 2011, 33, 379–387. [Google Scholar]
- Yang, Y.; Chen, Z.; Wu, X.; Zhang, X.; Yuan, G. Nanoporous cellulose membrane doped with silver for continuous catalytic decolorization of organic dyes. Cellulose 2018, 25, 2547–2558. [Google Scholar] [CrossRef]
- Escárcega-González, C.E.; Garza-Cervantes, J.A.; Vázquez-Rodríguez, A.; Morones-Ramírez, J.R. Bacterial Exopolysaccharides as Reducing and/or Stabilizing Agents during Synthesis of Metal Nanoparticles with Biomedical Applications. Int. J. Polym. Sci. 2018, 2018, 7045852. [Google Scholar] [CrossRef]
- Kingkaew, J.; Kirdponpattara, S.; Sanchavanakit, N.; Pavasant, P.; Phisalaphong, M. Effect of molecular weight of chitosan on antimicrobial properties and tissue compatibility of chitosan-impregnated bacterial cellulose films. Biotechnol. Bioprocess Eng. 2014, 19, 534–544. [Google Scholar] [CrossRef]
- Lei, J.; McClelland, A.; Zeng, T.H. Synthesis of Silver Nanoparticles by Vitamin C for Public Health Applications. In Proceedings of the 2022 IEEE 22nd International Conference on Nanotechnology (NANO), Palma de Mallorca, Spain, 4–8 July 2022; pp. 488–491. [Google Scholar]
- Han, Y.; Wu, X.; Zhang, X.; Zhou, Z.; Lu, C. Reductant-Free Synthesis of Silver Nanoparticles-Doped Cellulose Microgels for Catalyzing and Product Separation. ACS Sustain. Chem. Eng. 2016, 4, 6322–6331. [Google Scholar] [CrossRef]
- Kulikouskaya, V.; Hileuskaya, K.; Kraskouski, A.; Kozerozhets, I.; Stepanova, E.; Kuzminski, I.; You, L.; Agabekov, V. Chitosan-capped silver nanoparticles: A comprehensive study of polymer molecular weight effect on the reaction kinetic, physicochemical properties, and synergetic antibacterial potential. SPE Polym. 2022, 3, 77–90. [Google Scholar] [CrossRef]
- Kim, J.; Cai, Z.; Lee, H.S.; Choi, G.S.; Lee, D.H.; Jo, C. Preparation and characterization of a Bacterial cellulose/Chitosan composite for potential biomedical application. J. Polym. Res. 2011, 18, 739–744. [Google Scholar] [CrossRef]
- Menichetti, A.; Mavridi-Printezi, A.; Mordini, D.; Montalti, M. Effect of Size, Shape and Surface Functionalization on the Antibacterial Activity of Silver Nanoparticles. J. Funct. Biomater. 2023, 14, 244. [Google Scholar] [CrossRef] [PubMed]
- Lee, K.-S.; El-Sayed, M.A. Gold and Silver Nanoparticles in Sensing and Imaging: Sensitivity of Plasmon Response to Size, Shape, and Metal Composition. J. Phys. Chem. B 2006, 110, 19220–19225. [Google Scholar] [CrossRef]
- Bolla, P.A.; Huggias, S.; Serradell, M.A.; Ruggera, J.F.; Casella, M.L. Synthesis and Catalytic Application of Silver Nanoparticles Supported on Lactobacillus kefiri S-Layer Proteins. Nanomaterials 2020, 10, 2322. [Google Scholar] [CrossRef]
- Feng, Y.; Zhang, X.; Shen, Y.; Yoshino, K.; Feng, W. A mechanically strong, flexible and conductive film based on bacterial cellulose/graphene nanocomposite. Carbohydr. Polym. 2012, 87, 644–649. [Google Scholar] [CrossRef] [PubMed]
- Zhu, C.; Li, F.; Zhou, X.; Lin, L.; Zhang, T. Kombucha-synthesized bacterial cellulose: Preparation, characterization, and biocompatibility evaluation. J. Biomed. Mater. Res. A 2014, 102, 1548–1557. [Google Scholar] [CrossRef] [PubMed]
- Jyoti, K.; Baunthiyal, M.; Singh, A. Characterization of silver nanoparticles synthesized using Urtica dioica Linn. leaves and their synergistic effects with antibiotics. J. Radiat. Res. Appl. Sci. 2016, 9, 217–227. [Google Scholar] [CrossRef]
- Cui, Q.; Zheng, Y.; Lin, Q.; Song, W.; Qiao, K.; Liu, S. Selective oxidation of bacterial cellulose by NO2–HNO3. RSC Adv. 2014, 4, 1630–1639. [Google Scholar] [CrossRef]
- Mugesh, S.; Kumar, T.; Murugan, M. An unprecedented bacterial cellulosic material for defluoridation of water. RSC Adv. 2016, 6, 104839–104846. [Google Scholar] [CrossRef]
- Song, S.; Liu, Z.; Abubaker, M.; Ding, L.; Zhang, J.; Yang, S.; Zengjie, F. Antibacterial polyvinyl alcohol/bacterial cellulose/nano-silver hydrogels that effectively promote wound healing. Mater. Sci. Eng. C. 2021, 126, 112171. [Google Scholar] [CrossRef]
- Sarkar, D.; Ghosh, C.K.; Mukherjee, S.; Chattopadhyay, K.K. Three Dimensional Ag2O/TiO2 Type-II (p–n) Nanoheterojunctions for Superior Photocatalytic Activity. ACS Appl. Mater. Interfaces 2013, 5, 331–337. [Google Scholar] [CrossRef] [PubMed]
- Supanakorn, G.; Taokaew, S.; Phisalaphong, M. Multifunctional Cellulosic Natural Rubber and Silver Nanoparticle Films with Superior Chemical Resistance and Antibacterial Properties. Nanomaterials 2023, 13, 521. [Google Scholar] [CrossRef]
- Cai, Z.; Kim, J. Bacterial cellulose/poly(ethylene glycol) composite: Characterization and first evaluation of biocompatibility. Cellulose 2010, 17, 83–91. [Google Scholar] [CrossRef]
- Gleadall, A. Mechanical properties of biodegradable polymers for medical applications. In Modelling Degradation of Bioresorbable Polymeric Medical Devices; Pan, J., Ed.; Woodhead Publishing: London, UK, 2015; pp. 163–199. [Google Scholar]
- Teixeira, S.; Reis, E.; Apati, G.; Meier, M.; Nogueira, A.; Formolo Garcia, M.; Schneider, A.; Pezzin, A.; Porto, L. Biosynthesis and Functionalization of Bacterial Cellulose Membranes with Cerium Nitrate and Silver Nanoparticles. Mater. Res. 2019, 22, e20190054. [Google Scholar] [CrossRef]
- Mohammadkazemi, F.; Azin, M.; Ashori, A. Production of bacterial cellulose using different carbon sources and culture media. Carbohydr. Polym. 2015, 117, 518–523. [Google Scholar] [CrossRef]
- de Araújo Júnior, A.M.; Braido, G.; Saska, S.; Barud, H.S.; Franchi, L.P.; Assunção, R.M.N.; Scarel-Caminaga, R.M.; Capote, T.S.O.; Messaddeq, Y.; Ribeiro, S.J.L. Regenerated cellulose scaffolds: Preparation, characterization and toxicological evaluation. Carbohydr. Polym. 2016, 136, 892–898. [Google Scholar] [CrossRef]
- Diab, M.A.; El-Sonbati, A.Z.; Bader, D.M.D. Thermal stability and degradation of chitosan modified by benzophenone. Spectrochim. Acta Part A Mol. Biomol. Spectrosc. 2011, 79, 1057–1062. [Google Scholar] [CrossRef] [PubMed]
- Watanabe, K.; Tabuchi, M.; Morinaga, Y.; Yoshinaga, F. Structural Features and Properties of Bacterial Cellulose Produced in Agitated Culture. Cellulose 1998, 5, 187–200. [Google Scholar] [CrossRef]
- Gelin, K.; Bodin, A.; Gatenholm, P.; Mihranyan, A.; Edwards, K.; Strømme, M. Characterization of water in bacterial cellulose using dielectric spectroscopy and electron microscopy. Polymer 2007, 48, 7623–7631. [Google Scholar] [CrossRef]
- Zawadzka, K.; Kądzioła, K.; Felczak, A.; Wrońska, N.; Piwoński, I.; Kisielewska, A.; Lisowska, K. Surface area or diameter—Which factor really determines the antibacterial activity of silver nanoparticles grown on TiO2 coatings? New J. Chem. 2014, 38, 3275–3281. [Google Scholar] [CrossRef]
- Wu, J.; Zheng, Y.; Song, W.; Luan, J.; Wen, X.; Wu, Z.; Chen, X.; Wang, Q.; Guo, S. In situ synthesis of silver-nanoparticles/bacterial cellulose composites for slow-released antimicrobial wound dressing. Carbohydr. Polym. 2014, 102, 762–771. [Google Scholar] [CrossRef]
- Xie, Y.; Liao, X.; Zhang, J.; Yang, F.; Fan, Z. Novel chitosan hydrogels reinforced by silver nanoparticles with ultrahigh mechanical and high antibacterial properties for accelerating wound healing. Int. J. Biol. Macromol. 2018, 119, 402–412. [Google Scholar] [CrossRef]
- Yin, I.X.; Zhang, J.; Zhao, I.S.; Mei, M.L.; Li, Q.; Chu, C.H. The Antibacterial Mechanism of Silver Nanoparticles and Its Application in Dentistry. Int. J. Nanomed. 2020, 15, 2555–2562. [Google Scholar] [CrossRef] [PubMed]
- Khorrami, S.; Zarrabi, A.; Khaleghi, M.; Danaei, M.; Mozafari, M.R. Selective cytotoxicity of green synthesized silver nanoparticles against the MCF-7 tumor cell line and their enhanced antioxidant and antimicrobial properties. Int. J. Nanomed. 2018, 13, 8013–8024. [Google Scholar] [CrossRef] [PubMed]
- Kingkaew, J.; Jatupaiboon, N.; Sanchavanakit, N.; Pavasant, P.; Phisalaphong, M. Biocompatibility and Growth of Human Keratinocytes and Fibroblasts on Biosynthesized Cellulose–Chitosan Film. J. Biomater. Sci. Polym. Ed. 2010, 21, 1009–1021. [Google Scholar] [CrossRef] [PubMed]

| Samples | Tg (°C) | 1st Decomposition | 2nd Decomposition | 3rd Decomposition | Residue at 600 °C (%) | |||
|---|---|---|---|---|---|---|---|---|
| Tmax (°C) | Δ Mass loss (%) | Tmax (°C) | Δ Mass loss (%) | Tmax (°C) | Δ Mass loss (%) | |||
| BC | −86.2 | 44.2 | 6.2 | 339.6 | 64.0 | 465.2 | 7.0 | 22.8 |
| BC-Ag(NaOH) | −87.9 | 44.2 | 5.9 | 172.9 | 5.6 | 280.3 | 45.1 | 43.0 |
| BC-Ag(Ascorbic) | −81.4 | 59.3 | 4.3 | 328.8 | 58.7 | - | - | 36.9 |
| BC-Ag(UV) | −86.1 | 73.2 | 4.6 | 182.5 | 8.2 | 350.6 | 59.8 | 27.4 |
| BC-Ag(Chitosan) | −86.1 | 65.5 | 8.9 | 241.4 | 17.6 | 354.4 | 35.8 | 37.6 |
| BC | BC-Ag (NaOH) | BC-Ag (Ascorbic) | BC-Ag (UV) | BC-Ag (Chitosan) | ||
|---|---|---|---|---|---|---|
| (A) | 0 h | 2.59 × 106 | 3.21 × 106 | 3.29 × 106 | 3.30 × 106 | 3.23 × 106 |
| 24 h | 7.72 × 106 | 0 | 0 | 0 | 0 | |
| Reduction (Log CFU/mL) | −7.41% | 100% | 100% | 100% | 100% | |
| (B) | 0 h | 1.76 × 106 | 3.53 × 106 | 3.55 × 106 | 3.57 × 106 | 3.52 × 106 |
| 24 h | 1.32 × 107 | 0 | 0 | 0 | 0 | |
| Reduction (Log CFU/mL) | −13.99% | 100% | 100% | 100% | 100% |
| Methods of Reduction | Advantages | Disadvantages |
|---|---|---|
| NaOH reduction | High silver content High conductivity High tensile strength and elongation at break High antibacterial activities | Low Young’s modulus |
| Ascorbic acid reduction | High Young’s modulus High crystallinity Increased thermal stability High antibacterial activities | Large AgNPs size Low elongation at break |
| UV irradiation reduction | No chemical reagents required High tensile strength and elongation at break High antibacterial activities | Low silver content Low Young’s modulus |
| Chitosan reduction | Small AgNPs size High water absorption capacity High antibacterial activities and improved wound healing properties due to chitosan [28,57] | Low conductivity Low tensile strength and elongation at break (brittle) Low crystallinity |
Disclaimer/Publisher’s Note: The statements, opinions and data contained in all publications are solely those of the individual author(s) and contributor(s) and not of MDPI and/or the editor(s). MDPI and/or the editor(s) disclaim responsibility for any injury to people or property resulting from any ideas, methods, instructions or products referred to in the content. |
© 2023 by the authors. Licensee MDPI, Basel, Switzerland. This article is an open access article distributed under the terms and conditions of the Creative Commons Attribution (CC BY) license (https://creativecommons.org/licenses/by/4.0/).
Share and Cite
Jenkhongkarn, R.; Phisalaphong, M. Effect of Reduction Methods on the Properties of Composite Films of Bacterial Cellulose-Silver Nanoparticles. Polymers 2023, 15, 2996. https://doi.org/10.3390/polym15142996
Jenkhongkarn R, Phisalaphong M. Effect of Reduction Methods on the Properties of Composite Films of Bacterial Cellulose-Silver Nanoparticles. Polymers. 2023; 15(14):2996. https://doi.org/10.3390/polym15142996
Chicago/Turabian StyleJenkhongkarn, Ratchanon, and Muenduen Phisalaphong. 2023. "Effect of Reduction Methods on the Properties of Composite Films of Bacterial Cellulose-Silver Nanoparticles" Polymers 15, no. 14: 2996. https://doi.org/10.3390/polym15142996
APA StyleJenkhongkarn, R., & Phisalaphong, M. (2023). Effect of Reduction Methods on the Properties of Composite Films of Bacterial Cellulose-Silver Nanoparticles. Polymers, 15(14), 2996. https://doi.org/10.3390/polym15142996

